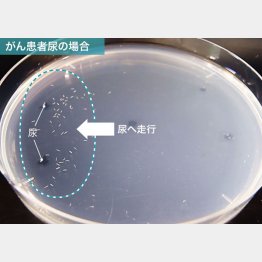

線虫が85%の確率でがん発見 来年1月の実用化で何が変わる
オシッコ一滴でがん発見――。こんな検査法が間もなく実用化される。東京のベンチャー企業「HIROTSUバイオサイエンス」が1日に発表した「N―NOSE」がそれ。土壌などに生息する微生物の線虫を使う。
線虫はすぐれた嗅覚を持っていて、がん患者の尿に含まれる特有のにおいに近づき、健康な人の尿からは逃げる。この性質を利用してがんに罹患しているかどうかを判定する仕組みだ。同社は九大助教だった広津崇亮社長によって2016年に設立され、開発を進めてきた。
「テレビ局の取材申し込みのほか、一般の方から『検査を受けたい。どうしたらいいのか』という問い合わせをいただいています。来年1月から実用化する方針です」(経営企画室広報担当者)
これまで約1400人の検体を使った臨床研究では、約85%の確率でがん患者を特定。ステージ0~1の初期のがんでは87%に達したという。検査費用は9800円の予定。胃がんや大腸がん、肺がんなど15種のがんを判定できるという。
「本当なのかと疑ってしまうほど画期的な検査法です」とは医学博士の左門新氏だ。